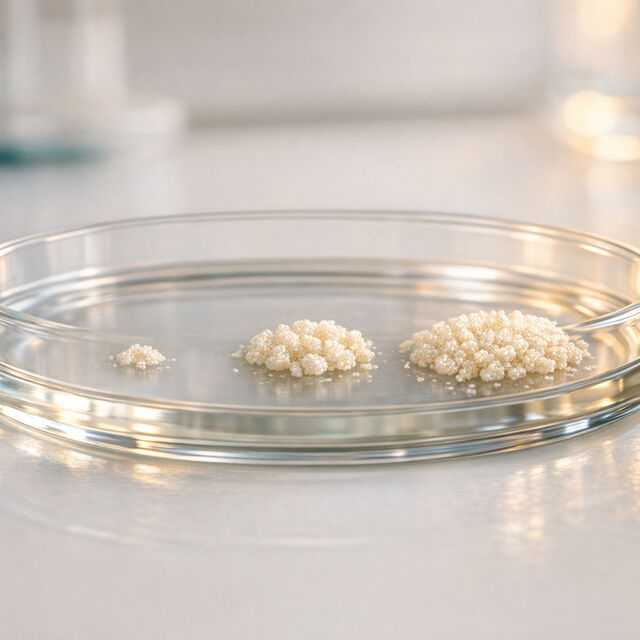
69a9d13a12de151ab02776c1 1772741645354

What is Stem Cell Expansion? Maximizing Your Cord Blood Investment
Stem cell expansion is a lab process that increases the number of hematopoietic stem cells (HSCs) from a single cord blood unit, making it possible to treat teenagers and adults who require higher cell doses for medical treatments. This technology, approved by the FDA in April 2023, can multiply stem cells by up to 50 times, improving recovery times and treatment outcomes. It addresses the limitations of standard cord blood storage, which often lacks enough cells for adult patients.
Key points:
- Cord blood stem cells are used to treat over 80 conditions, including blood cancers, anemias, and immune disorders.
- Challenges: Limited cell quantities in cord blood make it insufficient for many adult treatments.
- Solution: Stem cell expansion boosts cell counts, enabling faster recovery and reducing infection risks.
- Americord's CryoMaxx™ technology ensures cord blood is ready for future expansion, preserving all components for potential therapies.
- FDA-approved therapies, like Omisirge, show faster recovery times and lower infection rates.
Families investing in cord blood banking can now benefit from expansion technologies, which open doors to broader treatment options for multiple family members.
What Are Stem Cells and Why Does Cord Blood Matter?
Stem cells are the body's natural repair toolkit, capable of transforming into blood, bone, or muscle cells - essential for growth and healing. Cord blood, collected after birth, is packed with hematopoietic stem cells (HSCs), which are crucial for their adaptability and readiness in medical treatments. These cells can develop into various cell types and integrate effectively with the body's systems. As Professor David T. Harris from the University of Arizona explains:
"Cord blood stem cells are ideal for use in therapy on the basis of their 'age': they are primitive enough to become multiple cell types, yet mature enough to work within the existing framework of the body."
What sets cord blood apart is its adaptability. Unlike bone marrow transplants, which demand a perfect 8/8 HLA match, cord blood transplants succeed with less stringent 4/6 or 5/6 matches. These cells are also "naïve", meaning they’ve never been exposed to environmental toxins or aging effects. When stored, they’re readily available, eliminating the need for time-consuming donor searches. Additionally, cord blood transplants carry a lower risk of chronic graft-versus-host disease compared to transplants from adult donors. This flexibility and lower risk make cord blood a powerful resource with the potential for expanded therapeutic use.
Types of Stem Cells Found in Cord Blood
Cord blood is a rich source of hematopoietic stem cells (HSCs), which are the building blocks of the blood and immune systems. These cells develop into critical components like red blood cells, white blood cells, and platelets, making them essential for treating blood and immune-related conditions.
[Image of hematopoietic and mesenchymal stem cell differentiation]Beyond HSCs, cord blood also contains mesenchymal stem cells (MSCs), which have strong regenerative properties. Research led by Professor Meral Beksac at Ankara University shows that cord blood MSCs have a higher ability to multiply and can be cultured for longer periods compared to those from bone marrow. Additionally, placental tissue collected alongside cord blood offers placental stem cells, which are being explored for applications such as wound healing, burn treatments, and even neurological disorders.
How Cord Blood Stem Cells Are Used Today
Cord blood stem cells are currently used to treat over 80 medical conditions. These include:
- Blood cancers like Acute Myeloid Leukemia and Acute Lymphoblastic Leukemia
- Anemias such as Sickle Cell Disease, Fanconi Anemia, and Beta Thalassemia Major
- Lymphomas
- Inherited immune disorders like Severe Combined Immunodeficiency and Wiskott-Aldrich Syndrome
- Inherited metabolic disorders such as Krabbe Disease and Hurler Syndrome
Real-life cases illustrate the life-changing potential of cord blood. For instance, in 2020, a 10-year-old boy named Eli, born with Sickle Cell Disease, was successfully treated using cord blood stem cells from his younger brother, Gus. The family had stored Gus’s cord blood through the Americord Cares program. In another case, a 5-year-old girl named Olivia Fohs underwent a 15-minute procedure in January 2019 using her own banked cord blood stem cells, which significantly reduced the severity of her autism symptoms.
Globally, over 40,000 cord blood transplants have been performed, and more than 3 million cord blood units are stored worldwide. These figures emphasize the proven medical benefits of cord blood and hint at even greater possibilities as stem cell expansion techniques continue to advance.
Why Standard Cord Blood Storage Has Limits
Cord blood holds promise for medical treatments, but its potential is capped by the small volume collected from the umbilical cord and placenta. This limited amount reduces the number of stem cells available for storage, prompting the need for technologies that can expand these cells for broader therapeutic use.
On average, cord blood provides about 8.6 million total nucleated cells (TNC) per milliliter across 40–100 mL of collected volume. While this sounds like a lot, it’s far fewer hematopoietic stem cells (HSCs) compared to a bone marrow vs. cord blood stem cell transplant. As a result, a single cord blood collection often falls short for many adult treatments. EuroStemCell explains:
"A limitation of cord blood is that it contains fewer HSCs than a bone marrow donation does, meaning adult patients often require two volumes of cord blood for treatments."
When Stem Cell Quantity Falls Short
To be effective, treatments generally require about 25 million TNC per kilogram of body weight. For context, a 50-pound child might need around 65 mL of cord blood, while a 150-pound adult would require close to 195 mL - well beyond what a single cord blood collection can typically provide. This size-based limitation is a key reason why about 85% to 90% of cord blood units donated to public banks are rejected; they simply don’t contain enough cells to meet the needs of an average adult.
The Challenges of Limited Stem Cell Counts
When there aren’t enough stem cells, the body’s recovery process slows significantly. For example, neutrophil engraftment (the production of new blood cells) with cord blood often takes 21–28 days, compared to just 10–14 days with peripheral blood stem cells. Platelet recovery can stretch to 30–60 days, while other methods typically achieve this in 14–21 days.
This extended recovery period exposes patients to higher infection risks due to prolonged neutropenia. Historical data shows that delayed immune recovery can lead to transplantation-related mortality rates as high as 50%. In some cases, insufficient stem cells even result in transplant failure.
To overcome these challenges, clinicians may opt for double cord blood transplantation in adult patients, combining two units to achieve the necessary cell dose. However, this isn’t feasible for families who have stored only one child’s cord blood. These hurdles highlight the importance of stem cell expansion technologies, which aim to increase the number of cells in a single cord blood unit. By addressing these limitations, expansion techniques pave the way for better treatment outcomes.
How Stem Cell Expansion Works
Stem cell expansion is a lab technique designed to multiply hematopoietic stem and progenitor cells (HSPCs) outside the body, boosting their quantity for transplantation. This ex vivo expansion is particularly crucial for cord blood, as a single collection often lacks enough cells to effectively treat an adult patient.
The Expansion Process Explained
The process begins by isolating specific cells from a cord blood unit, typically CD133+ or CD34+ cells - key players in rebuilding the blood and immune systems. Scientists use immunomagnetic beads to separate these valuable cells from the rest of the cord blood.
Once isolated, these cells are cultured in a medium enriched with stimulatory cytokines for about 21 days. During this time, the cells multiply while retaining their primitive state. Meanwhile, the uncultured T-cell fraction, essential for immune recovery, is preserved separately. Before transplantation, these T-cells are recombined with the expanded cells.
A Phase I clinical trial published in July 2014 tested this approach with 11 adult patients suffering from hematologic malignancies. Conducted by researchers at Duke University Medical Center and Loyola University Medical Center, the trial showed impressive results. Patients receiving the expanded cells achieved neutrophil recovery in just 13 days, compared to the 25 days typically required with standard cord blood transplants. The 1-year survival rate for these patients reached 82%, paving the way for advancements like nicotinamide-based expansion.
Nicotinamide-Based Expansion Technology
Taking the expansion process further, nicotinamide-based technology enhances both the preservation and functionality of stem cells.
Nicotinamide, a small molecule, plays a key role in this process. It prevents stem cells from maturing too quickly during expansion, helping them retain their primitive state and long-term regenerative ability.
This method achieves a median 486-fold increase in total nucleated cells and a 72-fold increase in CD34+ cells. Beyond sheer numbers, nicotinamide improves the cells' ability to "home" to the bone marrow. This means they can better migrate toward stromal cell-derived factor 1 (SDF-1) and establish themselves effectively after infusion.
Dr. Mitchell E. Horwitz from Duke University Medical Center explains:
"Nicotinamide, a SIRT1 inhibitor, inhibits differentiation and enhances the functionality of HSPCs expanded in ex vivo cultures."
In a multicenter Phase I/II trial involving 36 patients with hematologic malignancies, the nicotinamide-expanded product, known as NiCord, delivered remarkable results. By day 42, 94% of patients had achieved neutrophil engraftment. The median time to neutrophil recovery was just 11.5 days - nearly half the 21 days required with standard cord blood transplants. This faster recovery reduces infection risks and leads to better outcomes overall. Follow-up data confirmed stable, long-term engraftment lasting 21 to 36 months post-transplant, demonstrating the durability of the expanded cells.
This innovative approach transforms a single cord blood unit into a powerful, future-ready resource, significantly enhancing its therapeutic potential.
Americord Registry's CryoMaxx™ Processing and Expansion Readiness
Americord Registry's CryoMaxx™ Processing offers a fresh approach to preparing cord blood for long-term storage, focusing on its future potential for therapeutic use. Instead of isolating specific cells before freezing, this method employs minimal manipulation, preserving the entire biological profile of the tissue. This means it safeguards not only stem cells but also growth factors and cytokines - key components for cell regeneration. These preserved molecules are essential for expansion technologies, paving the way for improved outcomes and more options for families in the future. Dr. Ankur Gandhi, Vice President of Research & Development at Americord, highlights the advantages:
"Our new processing method truly unlocks the full potential of the umbilical cord. Many blood banks focus only on the MSCs in cord tissue and pre-process them prior to cryopreservation, which limits a family's future treatment options. With CryoMaxx™ processing, our families can use their child's cord tissue stem cells for a wider range of therapeutic uses."
The process also incorporates 5-compartment storage for cord blood samples. This setup allows families to reserve part of the sample for immediate expansion procedures while keeping the rest cryopreserved at -196°F for potential future applications. By using customized manual processing, the method maximizes the total nucleated cell count and minimizes stem cell loss during preparation. Current research is delving into how these preserved niches may further enhance expansion results.
Preliminary studies suggest that placental tissues processed with CryoMaxx™ could help expand cord blood hematopoietic stem cells, addressing the challenge of insufficient cell quantities in standard cord blood units for adult patients. By maintaining the tissue's natural "niche" environment and avoiding premature breakdown, CryoMaxx™ ensures compatibility with emerging expansion technologies, making it a forward-thinking investment for families.
FDA-Approved Stem Cell Expansion Therapies
The FDA has given the green light to several stem cell expansion therapies, showcasing the tangible benefits of this technology. One standout is Omisirge (omidubicel-onlv), which earned FDA approval in April 2023 as the first expanded cord blood product. Created by Gamida Cell, it uses nicotinamide (a form of Vitamin B3) to boost hematopoietic stem cell numbers while preserving their ability to regenerate into various blood cell types. This innovation enhances the therapeutic potential of stored cord blood, offering greater benefits when needed most.
A Phase 3 clinical trial involving 125 patients aged 12–65 with blood cancers showed remarkable results. Median neutrophil recovery time dropped from 22 days to 12 days, leading to a decrease in severe infection rates from 60% to 39%. Additionally, only 39% of Omisirge patients experienced serious bacterial or fungal infections by day 100, compared to 60% in the standard cord blood group.
In December 2025, the FDA expanded Omisirge's approval to treat severe aplastic anemia (SAA) in patients aged 6 and older. In a related study, 12 out of 14 patients achieved early engraftment, with a median recovery time of just 11 days. Dr. Vinay Prasad, Chief Medical and Scientific Officer at the FDA's Center for Biologics Evaluation and Research, highlighted the importance of this milestone:
"This approval is revolutionary in the therapeutic landscape and fundamentally changes how we approach treatment for SAA, where earlier treatment has potential to alter one's life course."
These advancements in recovery times and infection reduction highlight the transformative potential of stem cell expansion for patients and their families.
Other notable FDA-approved therapies include Ryoncil (remestemcel-L), approved in December 2024 as the first mesenchymal stem cell therapy for pediatric steroid-refractory acute graft-versus-host disease, and Lyfgenia, approved in December 2023 for sickle cell disease. Lyfgenia achieved an impressive 88% resolution of vaso-occlusive events during clinical trials. These approvals affirm the ability of stem cell expansion technology to significantly improve treatment outcomes.
How Stem Cell Expansion Benefits Your Family
Better Treatment Results
Expanded stem cells can lead to much better outcomes in medical treatments. With higher stem cell counts, your body can rebuild crucial blood and immune system components faster. This means shorter hospital stays and a lower risk of infections.
The ability to achieve a 50-fold increase in hematopoietic cells through expansion technology plays a big role in speeding up engraftment. Engraftment is the critical phase where transplanted cells start producing new blood cells. The faster this happens, the less time a patient spends with a weakened immune system, reducing exposure to life-threatening complications.
Americord’s CryoMaxx™ processing and 5-compartment storage vials enhance these benefits. The multi-compartment design allows you to use portions of your stored cells for separate therapies. This flexibility means the cells can potentially be used for multiple family members over time instead of being limited to a single treatment.
More Treatment Options for the Future
Expanded stem cells also pave the way for a broader range of medical treatments in the future.
With expansion technology, cord blood becomes more than just a one-time resource - it turns into a powerful medical tool. Currently, cord blood stem cells are FDA-approved to treat over 80 medical conditions, including leukemias, lymphomas, and anemias. Beyond that, hundreds of clinical trials are exploring treatments for conditions like autism, cerebral palsy, diabetes, and Alzheimer's - diseases that impact a significant portion of the population. In fact, around 60% of American adults suffer from at least one chronic illness.
This technology doesn’t just benefit one individual - it can help multiple family members. Stem cells from your baby’s cord blood and tissue have the potential to assist siblings, parents, and even grandparents. This makes cord blood banking a valuable investment that can provide long-term benefits for your entire family.
Americord Family Plans for Cord Blood Banking
Americord offers five carefully designed family plans to help you take full advantage of stem cell expansion potential. Each plan includes the advanced CryoMaxx™ processing and a 5-compartment storage system, ensuring your stem cells are ready for future treatments. Here's a quick breakdown of the options:
- Essential Plan: Starts at $145/month for 24 months and covers cord blood banking.
- Advanced Plan: At $219/month for 24 months, this plan adds cord tissue banking, preserving both Hematopoietic Stem Cells (HSCs) and Mesenchymal Stem Cells (MSCs).
- Complete Plan: For $251/month over 24 months, this plan includes cord blood, cord tissue, and placental tissue banking.
For those looking for even more, the Ultimate Plan builds on the Complete Plan by adding newborn exosome banking. The Maximum Plan goes a step further, including maternal exosome banking alongside all Ultimate services. Americord is the first private biobank to offer exosome preservation, setting it apart in the industry.
Every plan is backed by Americord's $110,000 Quality Guarantee, the highest in the field. This guarantee covers the cost of an alternative stem cell source if your stored cells fail to engraft. Storage options include Annual, 20-Year, or Lifetime (78 years) durations, with promotional discounts available: 15% off multi-service 20-year plans and 30% off lifetime plans (valid through March 2026).
Plan Comparison Table
| Plan Name | Services Included | Monthly Payment (24 months) | Expansion Readiness Features |
|---|---|---|---|
| Essential | Cord Blood | $145 | CryoMaxx™ Processing, 5-Compartment Bag |
| Advanced | Cord Blood + Cord Tissue | $219 | CryoMaxx™ Processing, 5-Compartment Bag, 5 Tissue Vials, MSCs |
| Complete | Cord Blood + Cord Tissue + Placental Tissue | $251 | CryoMaxx™ Processing, 5-Compartment Bag, 10 Tissue Vials, MSCs |
| Ultimate | Cord Blood + Cord Tissue + Placental Tissue + Newborn Exosomes | Pricing available upon request | CryoMaxx™ Processing, 5-Compartment Bag, 10 Tissue Vials, MSCs, Exosomes |
| Maximum | All Ultimate services + Maternal Exosomes | Pricing available upon request | Full suite of perinatal tissues, MSCs, Exosomes |
All plans also require a $280 kit fee. Promotional rates are valid for 20-year storage plans as of March 2026.
These plans don’t just store your family’s cord blood - they prepare it for potential future treatments, offering peace of mind and a step toward protecting your family’s health.
Conclusion
Stem cell expansion adds tremendous potential to cord blood banking. By multiplying hematopoietic cells up to 50 times, this FDA-approved advancement makes cord blood a viable treatment option for teenagers and adults, meeting the higher cell dose requirements essential for successful engraftment.
Americord's CryoMaxx™ processing system and 5-compartment storage design ensure your cells are ready for multiple treatments. Paired with the $110,000 Quality Guarantee, this approach offers your family both peace of mind and a dependable safety net for future medical needs. It’s a process designed to maximize the value of your investment by preparing expanded cells for a variety of potential treatments.
With over 80 conditions treatable today and more than 500 clinical trials underway, regenerative medicine is evolving rapidly. Banking cord blood, alongside cord tissue and placental tissue, captures both hematopoietic and mesenchymal stem cells, giving your family access to a broader range of treatment possibilities.
Planning ahead is key. To ensure everything is in place, including collection kits and paperwork, make the decision to bank your baby’s cord blood by week 34 of pregnancy. Explore Americord’s plans to find one that fits your family’s goals and secure access to future-ready treatment options for years to come.
FAQs
Can my stored cord blood be expanded years later?
Stored cord blood can be multiplied years later through stem cell expansion techniques. These methods, which are still being researched and developed, focus on increasing the number of usable stem cells. This could make stored cord blood even more useful for treatments in regenerative medicine and other medical applications.
Is stem cell expansion used for autologous or family transplants?
Stem cell expansion plays a crucial role in both autologous (self-donated) and allogeneic (family-donated) transplants. By increasing the number of viable stem cells, it broadens treatment possibilities, whether the cells are sourced from the patient or a family member.
Does CryoMaxx™ processing affect eligibility for FDA-approved expansion?
CryoMaxx™ processing ensures that the eligibility for FDA-approved expansion remains unaffected. This method involves only minimal manipulation, which helps maintain the full potential of stem cells found in cord blood and tissue. It's important to note, though, that the approval of particular expansion techniques depends on FDA regulations.
The views, statements, and pricing expressed are deemed reliable as of the published date. Articles may not reflect current pricing, offerings, or recent innovations.